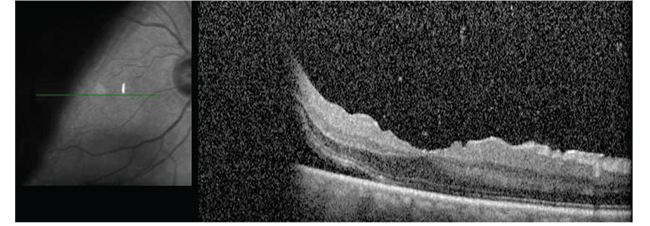
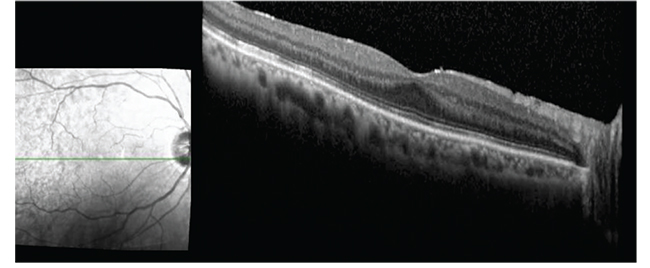

|
 |
Giant retinal tear is defined as a full-thickness circumferential break in the retina extending more than three clock hours or 90 degrees.1,2 GRTs arise from liquefaction of central vitreous and peripheral vitreous condensation with concomitant traction at the vitreous base. As a result, the retina tears circumferentially at the posterior vitreous base.3
For GRTs, the vitreous gel remains attached to the anterior flap of the retina, while the posterior retina moves freely and can fold upon itself.3 An important distinguishing factor between GRTs and dialyses is the status of the vitreous. In a dialysis, the
 |
vitreous is attached; in GRTs, the posterior vitreous is detached.
The incidence of GRTs is about 0.05: 100,000 per year.4 GRTs are mostly idiopathic; however, they can occur in the setting of trauma, cataract surgery, young age, high myopia, aphakia, pseudophakia or genetic mutations.2,5–10 The incidence of GRTs is estimated at 1.5 percent of rhegmatogenous retinal detachments (RRD),3 and proliferative vitreoretinopathy (PVR) may occur in cases of GRTs causing surgical failure or vision loss.
In 1962, Charles L. Schepens, MD, and colleagues were among the first to report on the difficulties of managing RD with GRT and the importance of performing timely surgery to minimize PVR.11 Despite advancements of surgical instruments and techniques, the management of RD with GRT is still a surgical challenge because of the technical difficulties and associated complications. In this article, we describe our opinions related to surgical management for RD with GRT.
Surgical management
Currently, pars plana vitrectomy is considered to be the conventional and standard procedure to repair RD with GRT.12 Unfolding GRTs can be achieved by using PPV followed by intraoperative perfluorocarbon liquid.
 |
|
| Figure 1. Preoperative wide-angle color photograph shows a retinal detachment with a giant retinal tear in a 66-year-old pseudophakic man. He experienced a shadow in the vision of his right eye for a week. Visual acuity was 20/30 OD, 20/25 OS. Optical coherence tomography preoperatively shows that the fovea is still attached. |
For pseudophakic eyes without PVR, PPV without scleral buckling is commonly used for RD with GRT. Without a scleral buckle, meticulous vitreous base trimming with scleral indentation and appropriate tamponade are usually adequate for vitreous-base dissection and GRT reapposition in cases with no significant PVR.6,13,14
 |
During PPV, a thorough vitrectomy is necessary. Pay attention to remove all the vitreous and traction to the retinal break. You can use PFCL to flatten the retina by using a dual-bore cannula. You can safely remove the anterior vitreous using the vitrectomy probe with the assistance of a scleral depressor when the posterior retina is stabilized. Incomplete removal of the anterior vitreous around the GRT might lead to redetachment and occurrence of PVR.
The fluid-air exchange is crucial in GRT vitrectomy. It’s important to remove the fluid anterior to the PFCL to prevent the slippage of the retina before the removal of PFCL. At the conclusion of the surgery, the eye can be filled with either gas or oil.
To add a buckle or not
We don’t recommend performing a lensectomy in a phakic GRT case because the modern small-gauge cutters can facilitate a thorough vitrectomy while respecting the crystalline lens.
Dr. Papakostas demonstrates the key steps in his technique for repairing a giant retinal tear.
Reports on adjuvant scleral buckle
The literature has shown a trend for higher anatomical success rates for patients who had adjuvant scleral buckle compared to those who had PPV only.16–22 However, these studies haven’t shown an advantage to using an encircling buckle in addition to PPV in terms of anatomical or visual acuity outcomes for RD with GRT.2,20 In addition, the reoperation rates were higher in cases with encircling buckles23,24 compared to those without encircling buckles.24,25
These studies generally had small sample sizes, and it’s difficult to compare these results due to the difference in the clinical characteristics of the study subjects and surgical techniques or procedures. More recently, John D. Pitcher, MD, and colleagues reported that adding a buckle did not significantly alter the success rates in GRT associated RDs.26
Gas or oil?
We usually use long-acting gas (14% C3F8) as a tamponade agent. Silicone oil can be used in cases of PVR or during a direct PFCL-SO exchange in cases of retinal slippage. David G. Charteris, MD, and his group at Moorfields Eye Hospital reported that eyes with gas as tamponade achieved better vision, had fewer postoperative complications and there was no difference in final attachment rates when compared to the eyes that received silicone oil.27
 |
|
| Figure 2. Six months postoperatively, photography and optical coherence tomography show the retina is attached. Visual acuity is 20/25. |
 |
Role of prophylactic laser
The use of laser in these cases is controversial because of the lack of evidence. One study from Italy with long-term follow-up showed that the group that received prophylactic laser had a higher incidence of tears with localized pre-equatorial RD and lower incidence of macula-off GRT RDs compared to the observation group.28 To get an unequivocal answer to this question would require a randomized trial consisting of 645 eyes in each group with a minimum follow-up of five years.
The bottom line
The prognosis of managing GRTs has improved over the recent years with better instrumentation and surgical visualization. Surgical advances include small-gauge PPV for managing RD with GRT.29–31
From our perspective, vitreoretinal surgeons should pay attention to the key steps of vitrectomy to increase the surgical success, including complete removal of the anterior vitreous and release of the traction on the retinal breaks, identifying and treating all breaks, and prevention of slippage of the retina. Although adjuvant buckling is associated with good anatomical success rates, emerging research has shown high anatomical success rates using PPV alone in managing RD with GRT.6,14,16,26,32
REFERENCES
1. Mathis A, Pagot V, Gazagne C, Malecaze F. Giant retinal tears: surgical techniques and results using perfluorodecalin and silicone oil tamponade. Retina. 1992; 12: S7–S10.
2. Kertes PJ, Wafapoor H, Peyman GA, Calixto Jr N, Thompson H. The management of giant retinal tears using perfluoroperhydrophenanthrene: a multicentre case series. Vitreon Collaborative Study Group. Ophthalmology. 1997:104:1159-1165.
3. Shunmugam M, Ang GS, Lois, N. Giant retinal tears. Surv Ophthalmol. 2014;59:192-216.
4. Berrocal MH, Chenworth ML, Acaba LA. Management of giant retinal tear detachments. J Ophthalmic Vis Res. 2017;12:93-7.
5. Scott IU, Murray TG, Flynn HW, Feuer WJ, Schiffman JC. Perfluoron Study Group. Outcomes and complications associated with giant retinal tear management usingperfluoro-n-octane. Ophthalmology. 2002; 109: 1828–1833.
6. Ambresin A, Wolfensberger TJ, Bovey EH. Management of giant retinal tears with vitrectomy, internal tamponade, and peripheral 360 degrees retinal photocoagulation. Retina. 2003; 23: 622e8.
7. Chang S, Lopez JM. Giant retinal tears and proliferative vitreoretinopathy. In: Ryan SJ, editor. Retina. 4th ed. St. Louis: Mosby; 2006. p. 2345-2351.
8. Ang GS, Townend J, Lois N. Interventions for prevention of giant retinal tear in the fellow eye. Cochrane Database Syst Rev. 2009;2:CD006909.
9. Aylward GW, Cooling RJ, Leaver PK. Trauma-induced retinal detachment associated with giant retinal tears. Retina. 1993;13:136-141.
10. Mehdizadeh M, Afarid M, Hagigi MS. Risk factors for giant retinal tears. J Ophthalmic Vis Res 2010;5:246-249.
11. Schepens CL, Dobble JG, Mc MJ. Retinal detachments with giant breaks: preliminary report. Trans Am Acad Ophthalmol Otolaryngol. 1962;66:471e9.
12. Gonzalez MA, Flynn HW, Smiddy WE, Albini TA, Tenzel P. Surgery for retinal detachment in patients with giant retinal tear: etiologies, management strategies, and outcomes. Ophthalmic Surg Lasers Imaging Retina. 2013; 44: 232–237.
13. Freeman HM, Castillejos ME. Current management of giant retinal breaks: results with vitrectomy and total air fluid exchange in 95 cases. Trans Am Ophthalmol Soc.1981;79:89e102.
14. Kreiger AE, Lewis H. Management of giant retinal tears without scleral buckling. Use of radical dissection of the vitreous base and perfluoro-octane and intraocular tamponade. Ophthalmology. 1992;99:491e7.
15. Ie D, Glaser BM, Sjaarda RN, et al. The use of perfluoro- octane in the management of giant retinal tears without proliferative vitreoretinopathy. Retina. 1994;14:323e8.
16. Chang S, Lincoff H, Zimmerman NJ, Fuchs W. Giant retinal tears. Surgical techniques and results using perfluorocarbon liquids. Arch Ophthalmol. 1989; 107:761–766.
17. Ghosh YK, Banerjee S, Savant V, Kotamarthi V, Benson MT, Scott RA et al. Surgical treatment and outcome of patients with giant retinal tears. Eye. 2004; 18: 996e1000.
18. Goezinne F, LAH EC, Berendschot TT, Gast ST, Liem AT, Lundqvist IL et al. Low redetachment rate due to encircling scleral buckle in giant retinal tears treated with vitrectomy and silicone oil. Retina. 2008; 28: 485–492.
19. Lee SY, Ong SG, Wong DWK, Ang CL. Giant retinal tear management: an Asian experience. Eye. 2009; 23: 601-605.
20. Al-Khairi AM, Al-Kahtani E, Kangave D, et al. Prognostic factors associated with outcomes after giant retinal tear management using perfluorocarbon liquids. Eur J Ophthalmol. 2008;18:270e7.
21. Unlu N, Kocaoglan H, Acar MA, et al. The management of giant retinal tears with silicone oil. Eur J Ophthalmol. 2003;13:192e5.
22. Verstraeten T, Williams GA, Chang S, et al. Lens-sparing vitrectomy with perfluorocarbon liquid for the primary treatment of giant retinal tears. Ophthalmology. 1995;102:17e20.
23. Bottoni F, Bailo G, Arpa P, et al. Management of giant retinal tears using perfluorodecalin as a postoperative short- term vitreoretinal tamponade: a long-term follow-up study. Ophthalmic Surg. 1994; 25:365e73.
24. Glaser BM, Carter JB, Kuppermann BD, et al. Perfluorooctane in the treatment of giant retinal tears with proliferative vitreoretinopathy. Ophthalmology. 1991;98:1613e21.
25. Rofail M, Lee LR. Perfluoro-n-octane as a postoperative vitreoretinal tamponade in the management of giant retinal tears. Retina. 2005;25:897e901.
26. Pitcher JD 3rd, Khan MA, Storey PP, et al. Contemporary management of rhegmatogenous retinal detachment due to giant retinal tears: A consecutive case series. Ophthalmic Surg Lasers Imaging Retina. 2015; 46: 566–570.
27. Banerjee PJ, Chandra A, Petrou P, Charteris DG. Silicone oil versus gas tamponade for giant retinal tear-associated fovea- sparing retinal detachment: A comparison of outcome. Eye. 2017;31:1302-1307.
28. Ripandelli G, Rossi T, Cacciamani A, Scarinci F, Piaggi P, Stirpe M. Laser prophylactic treatment of the fellow eye in giant retinal tears: Long-term follow-up. Retina. 2016;36:962-926.
29. Oliveira LB, Reis PA. Silicone oil tamponade in 23-gauge transconjunctival sutureless vitrectomy. Retina. 2007;27:1054e8.
30. Riemann CD, Miller DM, Foster RE, et al. Outcomes of transconjunctival sutureless 25-gauge vitrectomy with silicone oil infusion. Retina. 2007;27:296e303.
31. Tsang CW, Cheung BT, Lam RF, et al. Primary 23-gauge transconjunctival sutureless vitrectomy for rhegmatogenous retinal detachment. Retina. 2008;28:1075e81.
32. Batman C, Cekic O. Vitrectomy with silicone oil or long- acting gas in eyes with giant retinal tears: Long-term follow-up of a randomized clinical trial. Retina. 1999;19:188e92.



